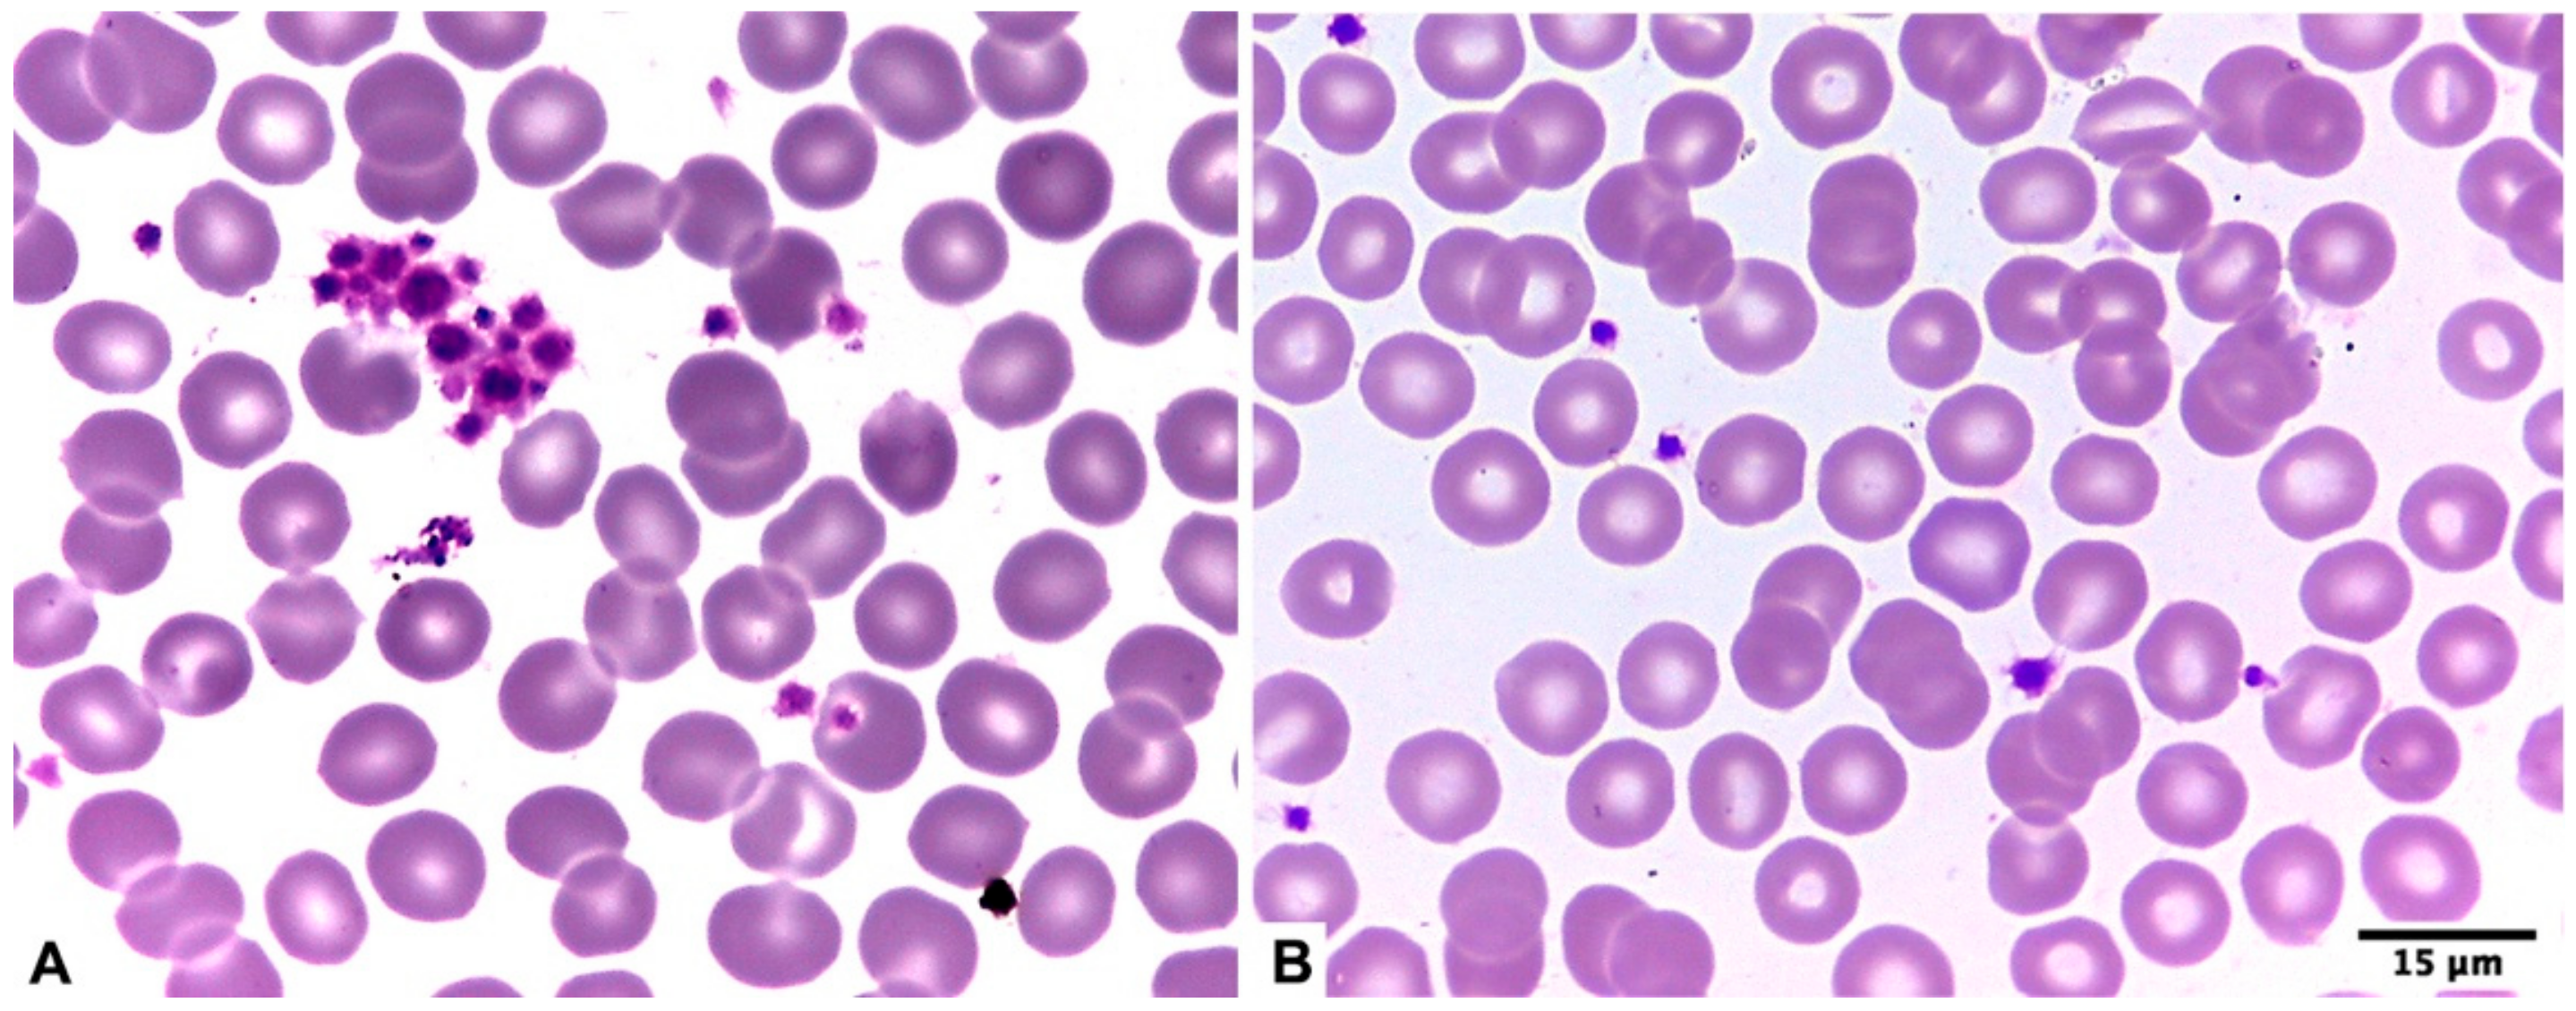
Diagnostics 15 01050 g001 Diagnostics 15 01050 g001
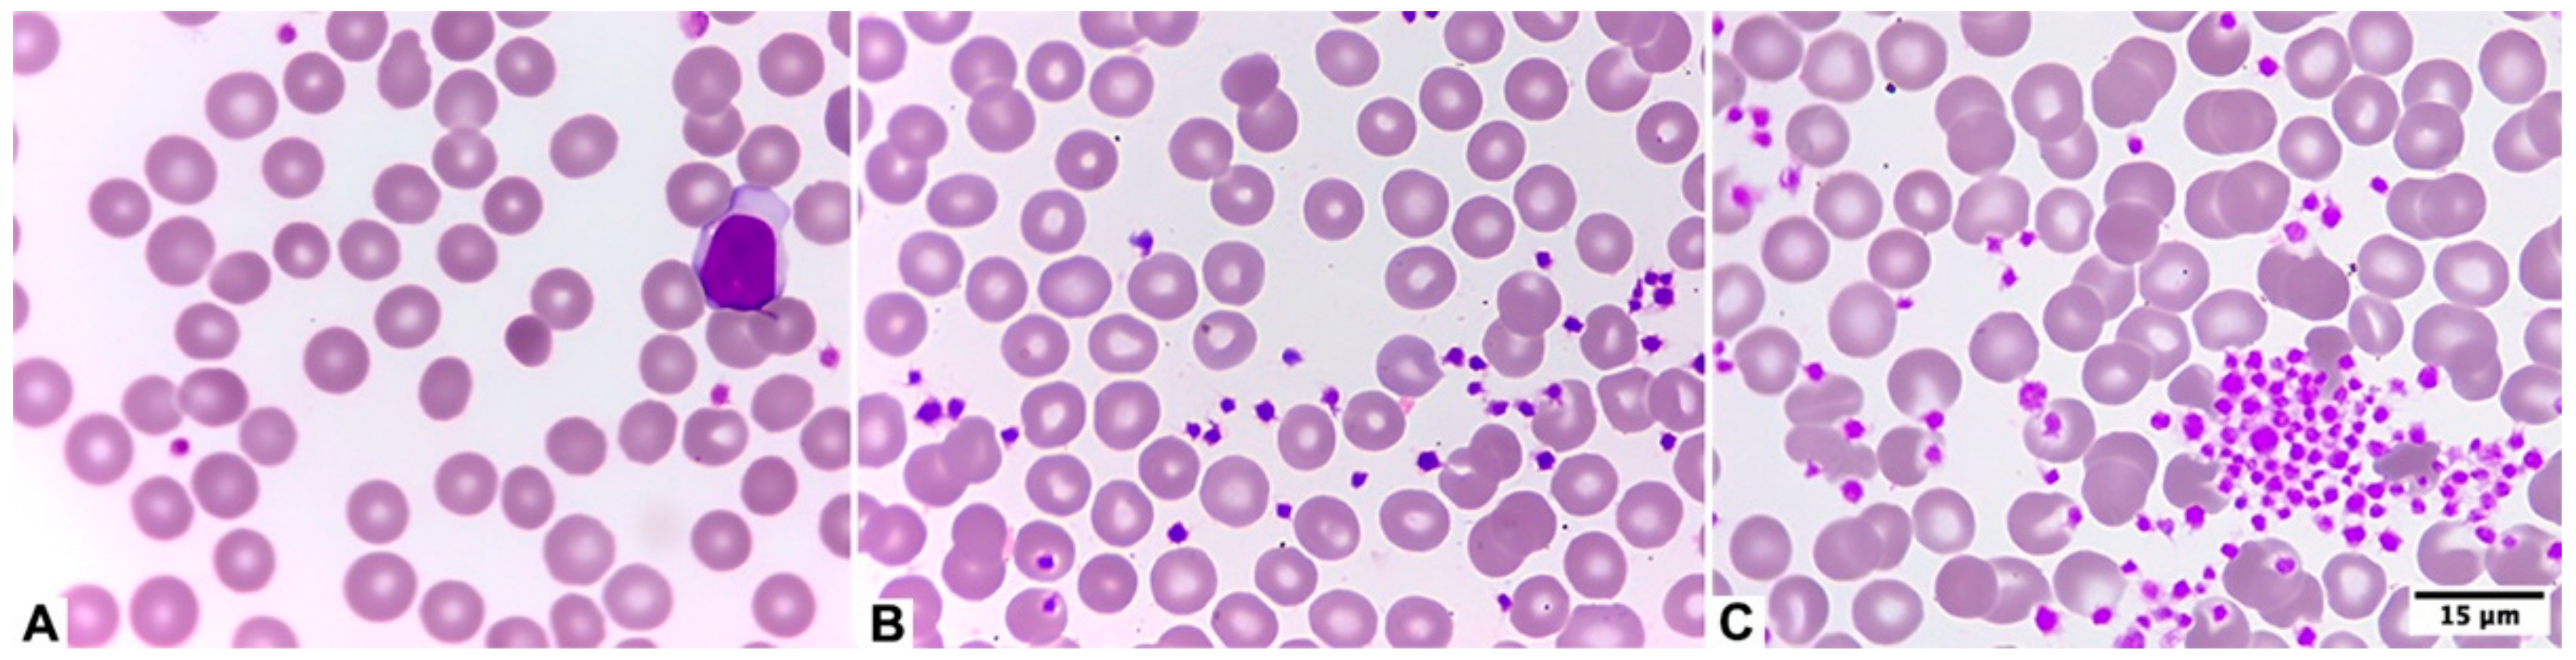
Diagnostics 15 01050 g002 Diagnostics 15 01050 g002

First Report of Ethylenediaminetetraacetic Acid-Dependent Pseudo-Thrombocytopenia in Chile: Prevalence and Laboratory Insights
Abstract
1. Introduction
2. Materials and Methods
- Decreased platelet count (<150 × 109/L) in the EDTA-dipotassium (EDTA/K2) tube (CML Biotech Ltd., Angamaly, India) processed on the Mindray BC-5380 hematology analyzer (Mindray Medical International Ltd., Shenzhen, China) in patients without clinical signs of thrombocytopenia/thrombocytopathies and without previous platelet counts;
- A significant reduction in platelet count (delta check ≥ 40%) compared to the patient’s previous result. It should be noted that this rule applies when comparing the results of the platelet count of the same patient obtained at different times (intra-individual biological variability);
- The presence of alarms associated with platelet and/or leukocyte counts added to an alteration in the platelet histogram.
3. Results
4. Discussion
5. Conclusions
Author Contributions
Funding
Institutional Review Board Statement
Informed Consent Statement
Data Availability Statement
Conflicts of Interest
References
- Ashworth, I.; Thielemans, L.; Chevassut, T. Thrombocytopenia: The good, the bad and the ugly. Clin. Med. 2022, 22, 214–217. [Google Scholar] [CrossRef] [PubMed]
- Swain, F.; Bird, R. How I approach new onset thrombocytopenia. Platelets 2020, 31, 285–290. [Google Scholar] [CrossRef] [PubMed]
- Schuff-Werner, P.; Mansour, J.; Gropp, A. Pseudo-thrombocytopenia (PTCP). A challenge in the daily laboratory routine? J. Lab. Med. 2020, 44, 295–304. [Google Scholar] [CrossRef]
- Wang, L.; Wang, H.; Liang, H.; Ren, Z.; Gao, L. Giant Platelets Induce Double Interference in Complete Blood Count. Ann. Clin. Lab. Sci. 2019, 49, 554–556. [Google Scholar]
- Ghariani, I.; Braham, N.; Hamzaoui, S.; Bekir, L. Platelet satellitism in autoimmune hemolytic anemia. Curr. Res. Transl. Med. 2017, 65, 61–64. [Google Scholar] [CrossRef]
- Urrechaga, E.; Fernández, M. Pseudothrombocytopenia and leukocyte scattergrams: A case report. J. Lab. Precis. Med. 2022, 7, 35. [Google Scholar] [CrossRef]
- Gowland, E.; Kay, H.E.; Spillman, J.C.; Williamson, J.R. Agglutination of platelets by a serum factor in the presence of EDTA. J. Clin. Pathol. 1969, 22, 460–464. [Google Scholar] [CrossRef]
- Maslanka, K.; Marciniak-Bielak, D.; Szczepinski, A. Pseudothrombocytopenia in blood donors. Vox Sang. 2008, 95, 349. [Google Scholar] [CrossRef]
- Froom, P.; Barak, M. Prevalence and course of pseudothrombocytopenia in outpatients. Clin. Chem. Lab. Med. 2011, 49, 111–114. [Google Scholar] [CrossRef]
- Lardinois, B.; Favresse, J.; Chatelain, B.; Lippi, G.; Mullier, F. Pseudothrombocytopenia—A Review on Causes, Occurrence and Clinical Implications. J. Clin. Med. 2021, 10, 594. [Google Scholar] [CrossRef]
- Mao, W.Y.; Huo, M.; Ye, S.D.; Gong, W.B. Experimental analysis and countermeasures for EDTA-dependent Pseudothrombocytopenia. Zhongguo Shi Yan Xue Ye Xue Za Zhi 2014, 22, 1345–1347. [Google Scholar] [PubMed]
- Sinha, S.K.; Mandal, P.K.; Mallick, J. Pseudothrombocytopenia—A caveat. J. Indian Med. Assoc. 2011, 109, 476–478. [Google Scholar] [PubMed]
- Lin, J.; Luo, Y.; Yao, S.; Yan, M.; Li, J.; Ouyang, W.; Kuang, M. Discovery and Correction of Spurious Low Platelet Counts due to EDTA-Dependent Pseudothrombocytopenia. J. Clin. Lab. Anal. 2015, 29, 419–426. [Google Scholar] [CrossRef] [PubMed]
- Ohashi-Fukuda, N.; Inokuchi, R.; Sato, H.; Nakamura, K.; Iwagami, M.; Wada, T.; Jona, M.; Hisasue, T.; Nakajima, S.; Yahagi, N. Poorer prognosis with ethylenediaminetetraacetic acid-dependent pseudothrombocytopenia: A single-center case-control study. Medicine 2015, 94, e674. [Google Scholar] [CrossRef]
- Pujol-Moix, N.; Muñiz-Díaz, E.; Español, I.; Mojal, S.; Soler, A.; Souto, J.C. Pseudothrombocytopenia, beyond a laboratory phenomenon: Study of 192 cases. Ann. Hematol. 2023, 102, 1363–1374. [Google Scholar] [CrossRef]
- Benavente, R.; Araya, P.; Irausquín, M.; Peralta, F.; Jara, V. Pseudotrombocitopenia por ácido etilendiaminotetraacético (EDTA) e hipocalcemia severa inducida por ácido valproico: Reporte de un caso. In Proceedings of the XLII Congreso Chileno de Medicina Interna, Virtual, 30 September–2 October 2021; Libro de Resúmenes, Trabajos Libres. p. 133. Available online: https://www.smsextar.cl/archivos/resumen/libro_resumen_2021.pdf (accessed on 14 April 2025).
- Kopčinović, L.; Juričić, G.; Antončić, D.; Smaić, F.; Šimac, B.; Lapić, I.; Biljak, V. National recommendations of the Croatian Chamber of Medical Biochemists and Working group for Laboratory Hematology of the Croatian Society of Medical Biochemistry and Laboratory Medicine: Management of samples with suspected EDTA-induced pseudothrombocytopenia. Biochem. Med. 2024, 34, 030504. [Google Scholar]
- Krishnamurthy, V.; Shivamurthy, A.; Kumar, P.V. Platelet count in impedance-based hematology analyzer: Beware of trap! Asian J. Transfus. Sci. 2023, 17, 131–132. [Google Scholar] [CrossRef]
- Baccini, V.; Geneviève, F.; Jacqmin, H.; Chatelain, B.; Girard, S.; Wuilleme, S.; Vedrenne, A.; Guiheneuf, E.; Toussaint-Hacquard, M.; Everaere, F.; et al. Platelet Counting: Ugly Traps and Good Advice. Proposals from the French-Speaking Cellular Hematology Group (GFHC). J. Clin. Med. 2020, 9, 808. [Google Scholar] [CrossRef]
- Kratz, A.; Lee, S.H.; Zini, G.; Riedl, J.A.; Hur, M.; Machin, S.; International Council for Standardization in Haematology. Digital morphology analyzers in hematology: ICSH review and recommendations. Int. J. Lab. Hematol. 2019, 41, 437–447. [Google Scholar] [CrossRef]
- Lippi, G.; Plebani, M. EDTA-dependent pseudothrombocytopenia: Further insights and recommendations for prevention of a clinically threatening artifact. Clin. Chem. Lab. Med. 2012, 50, 1281–1285. [Google Scholar] [CrossRef]
- Provan, D.; Arnold, D.M.; Bussel, J.B.; Chong, B.H.; Cooper, N.; Gernsheimer, T.; Ghanima, W.; Godeau, B.; González-López, T.J.; Grainger, J.; et al. Updated international consensus report on the investigation and management of primary immune thrombocytopenia. Blood Adv. 2019, 3, 3780–3817. [Google Scholar] [CrossRef] [PubMed]
- Kashiwagi, H.; Kuwana, M.; Murata, M.; Shimada, N.; Takafuta, T.; Yamanouchi, J.; Kato, H.; Hato, T.; Tomiyama, Y.; Committee for Reference Guide for Diagnosis of Adult ITP Research Team for Coagulopathy and Other Intractable Diseases. Reference guide for the diagnosis of adult primary immune thrombocytopenia, 2023 edition. Int. J. Hematol. 2024, 119, 1–13. [Google Scholar] [CrossRef] [PubMed]
- Morales, M.; Moreno, A.; Mejía, M.; Bustamante, Y. Pseudotrombocitopenia EDTA-Dependiente: Rol del Laboratorio Clínico en la Detección y el Correcto Contaje Plaquetario. Rev. Fac. Med. 2001, 24, 55–61. [Google Scholar]
- Xiao, Y.; Yu, S.; Xu, Y. The Prevalence and Biochemical Profiles of EDTA-Dependent Pseudothrombocytopenia in a Generally Healthy Population. Acta Haematol. 2015, 134, 177–180. [Google Scholar] [CrossRef]
- Vicari, A.; Banfi, G.; Bonini, P.A. EDTA-dependent pseudothrombocytopaenia: A 12-month epidemiological study. Scand. J. Clin. Lab. Investig. 1988, 48, 537–542. [Google Scholar] [CrossRef]
- Mant, M.J.; Doery, J.C.; Gauldie, J.; Sims, H. Pseudothrombocytopenia due to platelet aggregation and degranulation in blood collected in EDTA. Scand. J. Haematol. 1975, 15, 161–170. [Google Scholar] [CrossRef]
- Noureen, A.; Ali, S.; Faisal, A.; Zaman, A.; Shanker, B.; Aslam, F. Pseudothrombocytopenia—Frequency, causes, and evaluation in a clinical laboratory. J. Muhammad Med. Coll. 2022, 12, 149–152. [Google Scholar] [CrossRef]
- Bizzaro, N. EDTA-dependent pseudothrombocytopenia: A clinical and epidemiological study of 112 cases, with 10-year follow-up. Am. J. Hematol. 1995, 50, 103–109. [Google Scholar] [CrossRef]
- Bartels, P.C.; Schoorl, M.; Lombarts, A.J. Screening for EDTA-dependent deviations in platelet counts and abnormalities in platelet distribution histograms in pseudothrombocytopenia. Scand. J. Clin. Lab. Investig. 1997, 57, 629–636. [Google Scholar] [CrossRef]
- Crimi, M.J.; Iribarne, P. Prevalencia y Causas de Pseudotrombocitopenia en un Hospital de Mendoza. Rev. Bioreview® 2019, 90, 6–22. [Google Scholar]
- Prates, R.; Viana, R.; Oliveira, M.; Souza, C. Pseudothrombocytopenia: Incidence and strategy for resolution in clinical laboratory. J. Bras. Patol. Med. Lab. 2017, 53, 382–387. [Google Scholar] [CrossRef]
- Kovacs, F.; Varga, M.; Pataki, Z.; Rigo, E. Pseudothrombocytopenia with multiple anticoagulant sample collection tubes. Interv. Med. Appl. Sci. 2016, 8, 181–183. [Google Scholar] [CrossRef] [PubMed]
- Witkowski, M.; Witkowska, M.; Tybura-Sawicka, M.; Majchrzak, A.; Robak, T.; Smolewski, P. Comparison of various diagnostic methods in assessing platelet count in patients with immune thrombocytopenia. Acta Haematol. Pol. 2021, 6, 584–589. [Google Scholar] [CrossRef]
- Arghirescu, S.; Bătăneanț, M.; Jinca, C.; Pașcalău, A.; Lelik, M.; Preja, M.; Ritli, L.; Ursu, E.; Șerban, M.; Ioniță, H. Multi-anticoagulant and EDTA-dependent pseudothrombocytopenia. Case reports on two pediatric patients. Rev. Română Med. Lab. 2014, 22, 191–198. [Google Scholar] [CrossRef][Green Version]
- Waseem, N.; Hanif, B.; Jabbar, J. Multicoagulant resistant pseudothrombocytopenia. J. Pak. Med. Assoc. 2021, 71, 2247–2249. [Google Scholar]
- Ghali, C.; Scavone, M.; Clerici, B.; Bossi, E.; Fioretti, A.; Pisetta, C.; Birocchi, S.; Vismara, G.; Vozzo, N.; Cattaneo, M.; et al. Time-dependent in vitro variations of platelet count in samples from subjects with EDTA-induced pseudothrombocytopenia: A comparative analysis across different anticoagulants. Br. J. Haematol. 2024, 204, 2125–2128. [Google Scholar] [CrossRef]
- Dumont, P.; Goussot, V.; David, A.; Lizard, S.; Riedinger, J.M. Identification and validation of a factor of commutability between platelet counts performed on EDTA and citrate. Ann. Biol. Clin. 2017, 75, 61–66. [Google Scholar] [CrossRef]
- Li, H.; Wang, B.; Ning, L.; Luo, Y.; Xiang, S. Transient appearance of EDTA-dependent pseudothrombocytopenia in a patient with 2019 novel coronavirus pneumonia. Platelets 2020, 31, 825–826. [Google Scholar] [CrossRef]
- Hsieh, A.T.; Chao, T.Y.; Chen, Y.C. Pseudothrombocytopenia associated with infectious mononucleosis. Arch. Pathol. Lab. Med. 2003, 127, 17–18. [Google Scholar] [CrossRef]
- Mori, M.; Kudo, H.; Yoshitake, S.; Ito, K.; Shinguu, C.; Noguchi, T. Transient EDTA-dependent pseudothrombocytopenia in a patient with sepsis. Intensive Care Med. 2000, 26, 218–220. [Google Scholar] [CrossRef]

| N° | Gender | Age (Years) | EDTA/K2 0 h (×109/L) | Citrate 0 h (×109/L) * | EDTA/K2 2–5 h (×109/L) | Citrate 2–5 h (×109/L) * | Reason for Consultation |
|---|---|---|---|---|---|---|---|
| 1 | Female | 60 | 223 | 227 | 69 (4.0 h) | 272 | Control post COVID-19 |
| 2 | Male | 18 | 237 | 254 | 96 (2.5 h) | 193 | Dermatological treatment for acne |
| 3 | Male | 16 | 214 | 223 | 80 (3.0 h) | 150 | Patient hospitalized awaiting discharge due to PIMS due to COVID-19 |
| 4 | Female | 12 | NA | NA | 45 (2.0 h) | 198 | Developmental delay |
| 5 | Female | 26 | 292 | 276 | 73 (2.0 h) | 202 | Thrombocytopenia without symptoms |
| 6 | Female | 31 | NA | NA | 91 (2.0 h) | 303 | Preventive health control |
| 7 | Female | 66 | 269 | 284 | 69 (2.0 h) | 198 | Thrombocytopenia without symptoms |
| 8 | Female | 49 | 329 | 339 | 137 (2.0 h) | 276 | Thrombocytopenia without symptoms |
| 9 | Female | 53 | 226 | 256 | 54 (2.0 h) | 168 | Thrombocytopenia without symptoms |
| 10 | Female | 55 | 182 | 176 | 38 (2.0 h) | 134 | Thrombocytopenia without symptoms |
| 11 | Female | 34 | NA | NA | 105 (5.0 h) | 278 | Preventive health control |
| 12 | Female | 81 | 180 | 199 | 72 (2.5 h) | 175 | Control for Parkinson’s disease and hypertension |
| EDTA/K2 0 h | Citrate 0 h | EDTA/K2 2–5 h | Citrate 2–5 h | p a | p b | p c | p d | p e | |
|---|---|---|---|---|---|---|---|---|---|
| Mean ± SD (×109/L) | 239.1 ± 49.5 | 248.2 ± 48.8 | 77.4 ± 27.3 | 212.2 ± 55.9 | <0.001 | 0.1401 | 0.6997 | 0.2666 | <0.001 |
| References | Country | Total Sample Size | Number and Frequency of Cases (n/%) | Platelet Count Cut-Off for Screening (×109/L) |
|---|---|---|---|---|
| [8] | Poland | 76,498 | 10/0.013% | <100 |
| [9] | Israel | 36,780 | 100/0.272% | <150 |
| [13] | China | 55,000 | 49/0.089% | <100 |
| [24] | Venezuela | 25,390 | 9/0.035% | <150 |
| [25] | China | 190,940 | 84/0.044% | <80 |
| [26] | Italy | 33,623 | 23/0.068% | <160 |
| [27] | Canada | 1300 | 3/0.231% | <150 |
| [28] | Pakistan | 1800 | 5/0.278% | <100 |
| [29] | Italy | 430,000 | 112/0.026% | <150 |
| [30] | Netherlands | 45,000 | 46/0.102% | <150 |
| [31] | Argentina | 7403 | 4/0.054% | <150 |
| [32] | Brazil | 28,435 | 56/0.197% | <150 |
Disclaimer/Publisher’s Note: The statements, opinions and data contained in all publications are solely those of the individual author(s) and contributor(s) and not of MDPI and/or the editor(s). MDPI and/or the editor(s) disclaim responsibility for any injury to people or property resulting from any ideas, methods, instructions or products referred to in the content. |
© 2025 by the authors. Licensee MDPI, Basel, Switzerland. This article is an open access article distributed under the terms and conditions of the Creative Commons Attribution (CC BY) license (https://creativecommons.org/licenses/by/4.0/).
Share and Cite
Balcázar-Villarroel, M.; Carmine, F.; Torrens, F.; Birditt, K.; Sandoval, C. First Report of Ethylenediaminetetraacetic Acid-Dependent Pseudo-Thrombocytopenia in Chile: Prevalence and Laboratory Insights. Diagnostics 2025, 15, 1050. https://doi.org/10.3390/diagnostics15081050
Balcázar-Villarroel M, Carmine F, Torrens F, Birditt K, Sandoval C. First Report of Ethylenediaminetetraacetic Acid-Dependent Pseudo-Thrombocytopenia in Chile: Prevalence and Laboratory Insights. Diagnostics. 2025; 15(8):1050. https://doi.org/10.3390/diagnostics15081050
Chicago/Turabian StyleBalcázar-Villarroel, Mario, Florencia Carmine, Francisco Torrens, Katherine Birditt, and Cristian Sandoval. 2025. "First Report of Ethylenediaminetetraacetic Acid-Dependent Pseudo-Thrombocytopenia in Chile: Prevalence and Laboratory Insights" Diagnostics 15, no. 8: 1050. https://doi.org/10.3390/diagnostics15081050
APA StyleBalcázar-Villarroel, M., Carmine, F., Torrens, F., Birditt, K., & Sandoval, C. (2025). First Report of Ethylenediaminetetraacetic Acid-Dependent Pseudo-Thrombocytopenia in Chile: Prevalence and Laboratory Insights. Diagnostics, 15(8), 1050. https://doi.org/10.3390/diagnostics15081050

